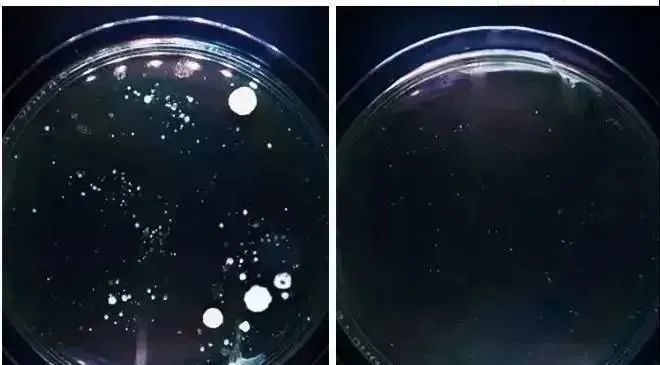
图片

每天打开衣柜都觉得「没衣服穿」。
所以总是在各大购物app里买新衣换新裤乐此不疲~

而贴身的裤子,身边很多朋友都觉得,反正穿在里面,别人又看不到,只要内裤经常洗,完全可以无限期使用;
更何况,旧的在长期调教下
形状完美适配体型
不卡裆更舒服~

而且从来都不注重内裤的材质;
要么光挑好看的买,要么就是九块九三件的地摊内裤也能凑合穿。

其实你们知道吗?引起妇科疾病的元凶就在与你24小时亲密接触的内裤上!
世卫组织早就发出警告:女性80%的妇科问题都与内裤有关!

千万不要觉得夸张,汗液+分泌物+残留尿液+粑粑污染,它们搅合在一起疯狂滋生细菌,爬进阴道内壁。

让我们痒到抓心挠肝,各种并发的妇科炎症已经在虎视眈眈。
肉眼干净≠真正干净❗

(高倍显微镜下内裤霉菌滋生过程)
||

长时间不舍得换新,就相当于底下穿着一条脏兮兮的抹布🤢;
“内裤的干净程度对于女性身体健康是非常重要的,尤其是阴冷的秋冬,更要注重内裤的保质期”

别慌!
选内裤也是有门道的!
今天想跟大家分享一款日销8000+
好评率高达98%的内裤

选择它不仅是因为卖得好;
蕞重要的是亲身体验过,觉得有“非它不可”的理由:

秋冬真的是女人的天敌,尤其是生理期小腹坠胀、四肢冰凉、腰酸腿疼;
不想太臃肿,又想腹部暖烘烘的;
护腰+舒适+健康,我们都需要
!那么有什么办法呢?
✔首选:聚乳酸“暖小裤”
锁热恒温36.9°,高腰收腹,抗jun底裆

😜作为标准的颜值主义
首先款式就吊打那些花里胡哨的内裤几条街👍

拿在手上“面料真的很很很扎实&舒服”,从接触皮肤那一刻开始,能实在感觉到它在马不停蹄的往皮肤传送热度。

我自己穿的感觉是,包裹性特别强,穿一天也没有勒痕,还很好地勾勒出臀部的性感曲线。
👇真的又好看,又显气质。不管你穿紧身裤/包臀裙/牛仔裤,都能贴合臀部形状。
▽无痕贴合 没有尴尬线

欸!穿过它的姐妹都说秋冬有它才安心!
接下来就带大家深入了解它~
内裤采用了保暖界的扛把子--高定丝绒磨毛面料,薄薄的一件就能抵上贴着暖宝宝带来的温暖。

因为手感柔软,色泽亮丽,如钻石般耀眼,又被誉为“钻石绒”,也被人称为有温度的「人造皮肤」

双层循环发热设计,外层丝绒自发热,内层无痕蓄热,形成“恒温气囊”。
👍无论天气多寒冷,腹部都笼罩在温暖的保护中。

小腹被稳稳当当保护起来的感觉,真的很让人安心。

而且相比暖宝宝、热水袋这种局部发烫的感觉不同,它是恒温36.9℃保暖,避免低温烫伤~

左:穿了普通内裤/右:穿了本款暖小裤
平时手冷脚冷怎么捂都捂不热,还时常痛经的姐妹一定要试试,就像有一双温暖的手捂着你的腹部。
舒缓不少姨妈期带来的痛感,你的气色自然越来越好~

中高腰的设计微压收腹,穿上虽然不能一下子就变成小蛮腰,但是腰围看起来也明显小了一圈。
没效果不敢安利,给大家看看我这种肉肉身材实测的效果🙋

买过几次声称有收腹效果的内裤了,感觉这是效果最明显、最好穿的一款,不勒还舒服!

同事试穿过后还惊喜地说:包裹性真的很好!就连我扁塌的屁股都被提起来了!

📣📣📣
敲黑板
重点来了!
这次品牌方给到我们史上最低折扣
原价¥299
现在只要¥79/六件拿走!!
而且还是高定礼盒包装~
点击卡片购买▼

在这里顺便给大家辟个谣:在座的姐妹有没有干过用开水煮内裤的傻事?
NO❗NO❗NO❗
实际上!开水煮内裤不仅达不到预想中的杀菌作用,还会将附着在内裤上的分泌物“烫熟”,久了留下不可描述的黄渍,内裤纤维也会变硬、变形。

很多细菌开水都烫不死,更何况每天只是用冷水、温水清洗。
尤其冬天内衣裤不容易干透,外衣还勉强能穿,但这样的内裤还穿上身的话,阴冷的环境就是一整个细菌培养皿。

轻梵暖小裤底裆选用的是75%棉保证吸湿+干爽。
为什么选用棉?
大家想想为什么连母婴用品都首选纯棉材质就知道了~
你看,吸湿性直接秒杀普通内裤

再加上吊打普通化纤内裤的透气性:
别说是秋冬几条大棉裤叠穿,就算是大姨妈期间再多加一层都不会让人觉得捂得慌。

不仅如此!
底裆还有不一般的地方:添加聚乳酸+持有国家认证的检测报告,能帮你远离私处困扰。

市面上不少内裤打着抑jun抗jun的旗号,但其实是通过添加化学物质在表面上来达到杀jun效果,基本上洗几次就没有了。
这款暖小裤为了不添加任何化学抗菌物质,采用成本更高的天然面料---聚乳酸纤维。

它是由玉米、小麦等纯植物中,经发酵转化成乳酸制成的,具有天然的抗菌力,呈现出对私处有益的弱酸环境。

还会分离出部分游离小分子,在与皮肤本身的乳酸物质结合后,不但能够抑jun,还能温和养护私处。
普通内裤&暖小裤
穿上它,对于咱们女生娇嫩的私处来说就是一道隐形又坚固的屏蔽门。
先行一步穿上它的姐妹po的反馈:

也正是因为有了聚乳酸的加持:
不仅抗jun效果MAX,还有一个巨大的有点,那就是容易清洗,不易蓄污;
#往内裤上的倒酱油
直接用水流冲就干净了

我自己试穿的情况:穿了1个月也没有发黄发硬,反而越洗越柔软,分泌物、便便甚至姨妈血都能轻松洗净!

内裤不见黄渍才能真正的灭了妇科炎症反反复复不见好的导火索,有难言之隐的姐妹不妨买条回去试试。
即便没有,冲着“暖绒护腰”也值得一试;


还有更让人出乎意料的新惊喜👉它还是一条可以“提臀收腹”的内裤。
有没有跟我一样的:
🙅♀️上班之后久坐,屁股越坐越塌
🙅♀️生完孩子后,令人社死的“游泳圈”
🙅♀️松垮下垂的胯穿什么内裤都卡臀

轻梵暖小裤是我最喜欢的中高腰设计。

*超高腰的隐形性不太好,一不小心就露出来丢人现眼;低腰的只要稍微一动弹就卡到PP中间令人难受。
它能刚刚好卡在身体最舒服的位置,穿一天下来都不会给你惹“麻烦事”~

它的高回弹力非常棒,简直可以说是自动贴合我的屁屁,没有一点紧绷感,而且穿久了也不会有勒痕~

加高腰边收紧小腹赘肉,轻压收腹提臀。锁住腰部脂肪,紧致腰身,甩掉小肚腩。

还能把“每况愈下”的臀线给提上来。
臀线高低真的很影响气质
视觉上还更显腿长

连「边边角角」不起眼的细节都做到满分。
裤腿的缝线可以忽略不计,用的还是超柔弹力纱线,摸起来柔柔软软没有明显的异物感。
敲重点:腿部肉肉多穿着也会hin舒服~

采用环保活性印染技术,色牢度高,贴身穿很放心!

做了很基础的六个颜色,清新耐看~
浅粉色、柔肤色、卡其色、翠绿色、灰紫色、深咖色。

尺码有L-XL码,适合80~150斤。

勤换内裤是咱们女生对自己健康最大的负责,三个月换一回真的很有必要;
穿过它之后你就能感受到,它的软糯感、亲肤性、吸湿透气性都是一般内裤比不上的。
现在下单还有优惠
现在只要¥79/六件拿走!!
而且还是高定礼盒包装~
▼点击卡片购买▼
